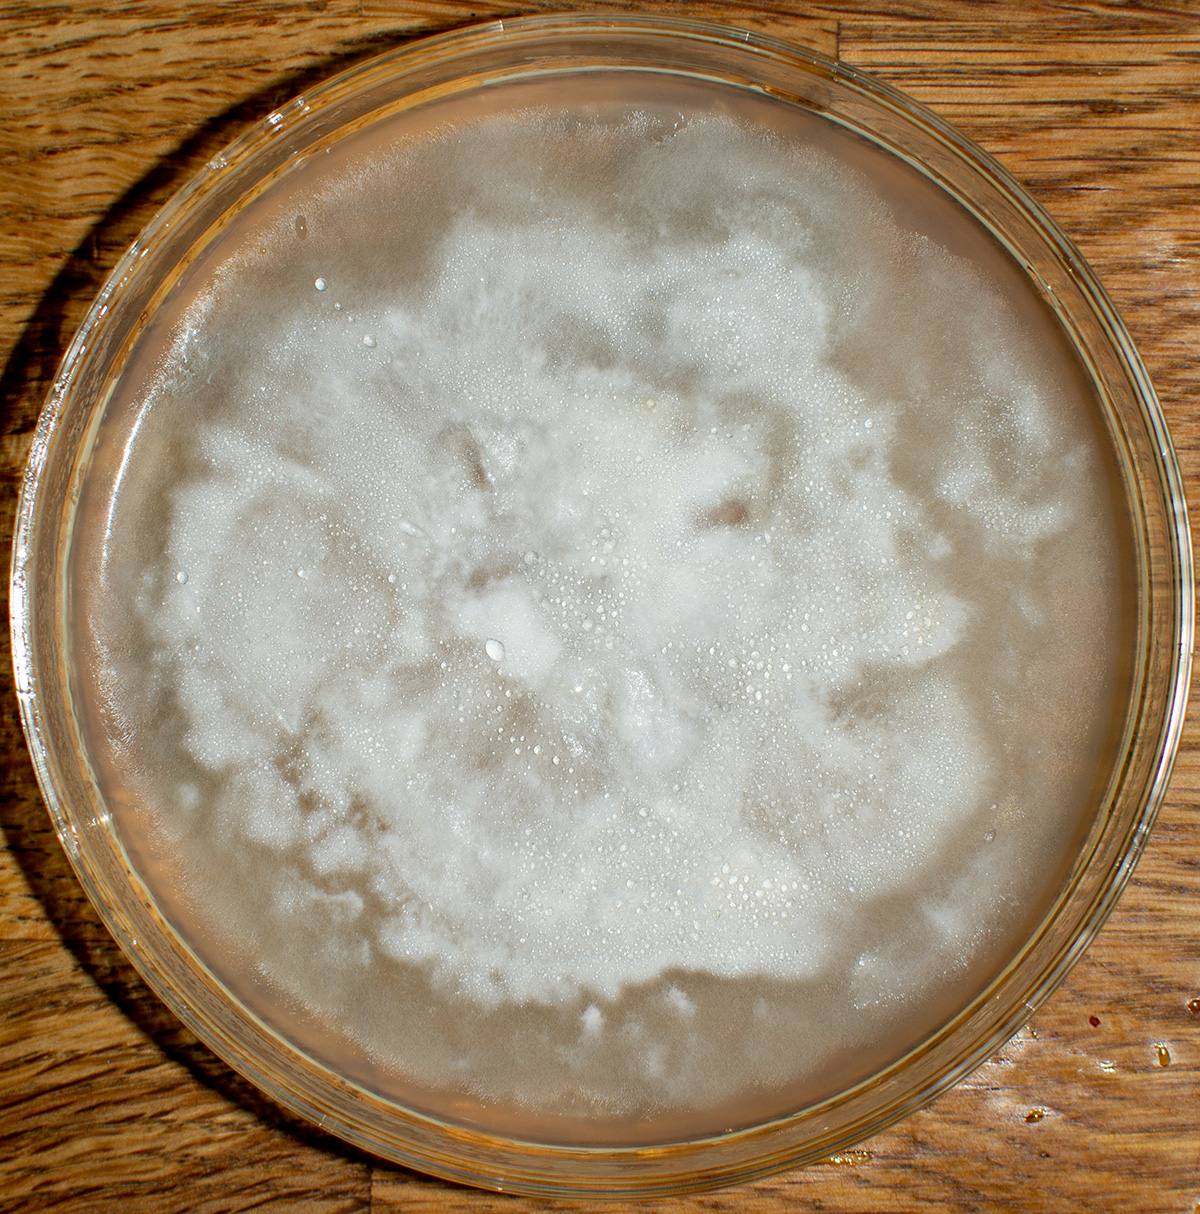
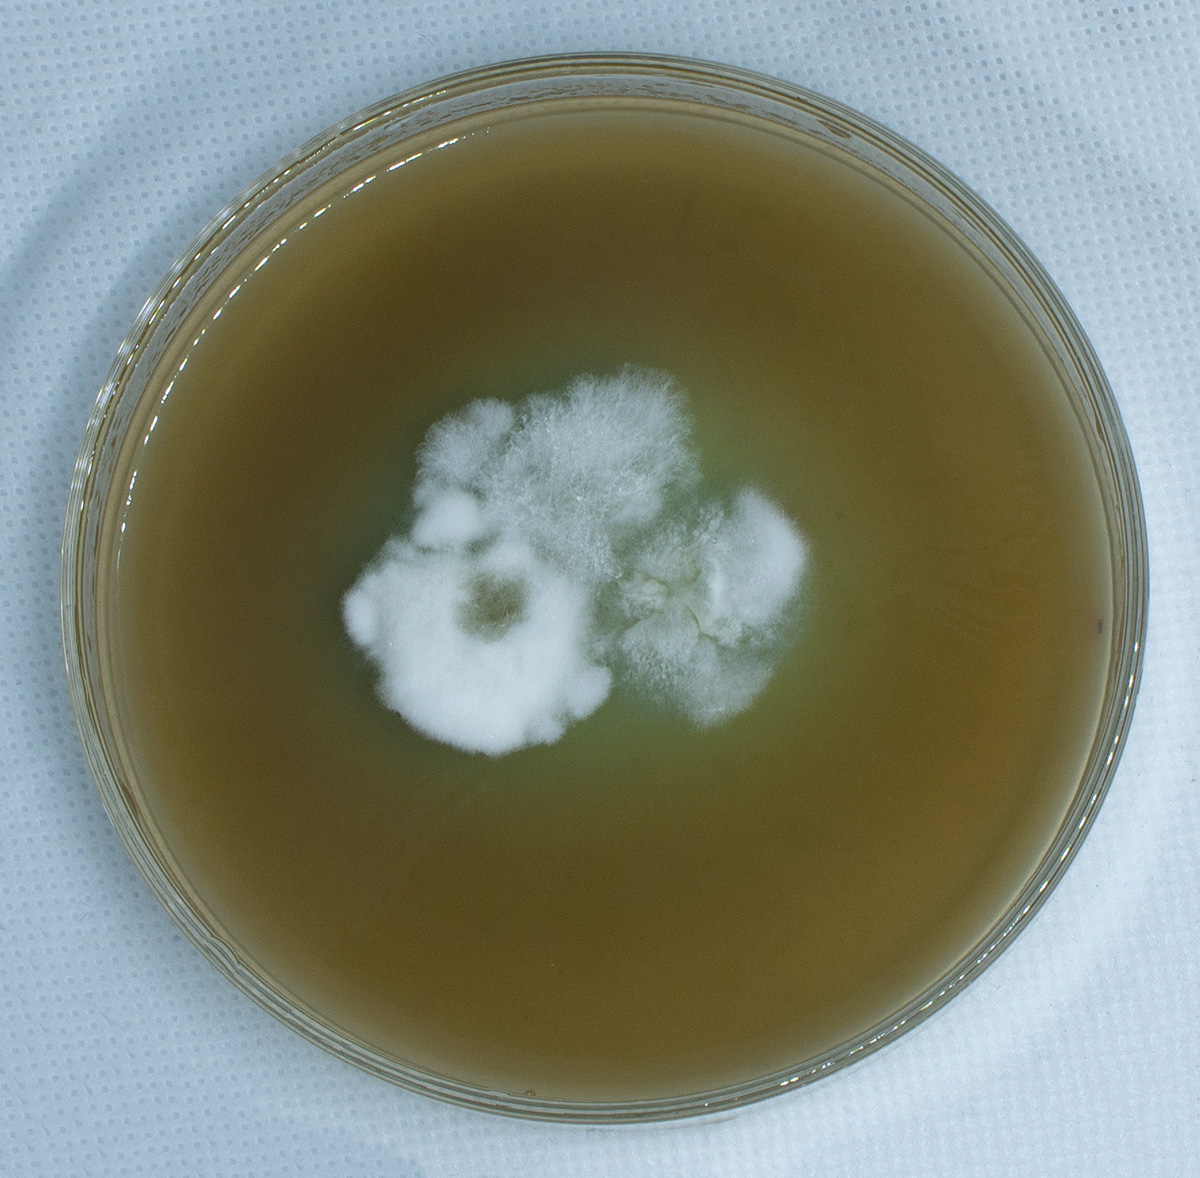

|

Panaeolus Cyanescens (PANCYAN)
The universal wind teacher
Aeolus is the Greek God of the winds and he can create violent storms just like the Panaeolus in a ceremony. These mushrooms are much more powerful then the Golden teachers and have less of a body drain.
Pan is the all pervasive and all including aspect of this mushroom.
There are 5 winds (Vayus) known in Yoga and the Panaeolus includes them all in a ceremony.
| Prana | Chest, head | Governs intake, inspiration, propulsion, forward momentum |
| Apana | Pelvis | Governs elimination, downward and outward movement |
| Samana | Navel | Governs assimilation, discernment, inner absorption, consolidation |
| Udana | Throat | Governs growth, speech, expression, ascension, upward movement |
| Vyana | Whole body | Governs circulation on all levels, expansiveness, pervasiveness |
All these 5 Winds are being cleansed by the Panaeolus Cyanescens - hence, it is the Universal Wind Teacher.
One of the first things in yoga you learn is that life energy and breathe are tied together. In the more advanced methods like rebirthing you will know without a doubt that life energy and breath link together.
Well the universal wind teacher goes even a step further in power and basically lets you merge with the winds itself.
Potency wise, these are the single most powerful mushroom on the planet.
-- -- --
Strains:
The jamaican strain is the easiest to grow and seems to produce an even pinset with an abundance of uniformly sized and shaped fruits - favorate
Hawaiian OgreBoy (easier to grow, also contains high amounts of psilocybe) |
Cambodginiensis (strongest) |
Tropicalis (difficult to grow) |
Australia (less psilocybe - more psilocin so works very fast but not so good dried) |
Goliath (The biggest) |
Florida |
Estero (Florida - easiest to grow) |
Jamaica (easier to grow) |
--
To grow these require 26C temperature or higher and high humidity.
Below you see how you can be succesful.
It requires some prior knowledge found in the gowing room 1 page
Panaeolus Cyanescens Jamaica
Spore swap
Spore swap from Viking spore |
 |
- Put spores on petri dish, no need to zigzag the plate, just dip in the middle. Use MEA or:
Agar Plate 500 ml destilled water or chlorine free tap water 10 grams organic agar-agar |
Put them in a heated propagator or incubator @ 26 C
Make sure the plates are not directly touching the bottom surface, so put them on a rack or use a sealed container that is not flat on the bottom but is lifted a bit.
This way the plates do not get burned by the heated propagator and stay evenly warm. Also no condensation and contamination problems if you leave them inside a sealed box.

Transfer until clean fast growth. Do not wait for rhizomorphic growth as these pancyans remain more Tomentose (fluffy). However the thick fluffy growing mycelium will overgrow when mixed in substrate, so you want the flat fast growing mycelium.
You can sector them:
Result of one of the dishes after spore swap @ 28C day 10 |
Backside of same dish to find good sectors to put on new dish |
The thick white mycelium was incubated at 27C while the thin outisde was incubated at 22C. It grows much slower and thinner in colder temperatures.
Grain Jar 50% biological Rey berries (Rogge) 50% biological Millet (Gierst) |
- Soak ryeberries for 4 days and millet for 2 days - add a bit of feed gypsum.
- Fill jars 3/4, then autoclave for 2.5 hours. (so no cooking)
- Add the agar to the mix and let it sit @ 26 C (use mushroom bags or Duran bottle with filter)
- 30% white, shake jars. (after shaking it is normal that about 1/4 of the jars will stall. Do not use them.)
- 100% white, time for mixing. Use 25% grain spawn and 75% Substrate.
Substrate: 70 % horse manure (sun dried and grass fed not grain fed) 20% dried chopped grass 10% vermiculite 5% of total weight gypsum Bring to field capacity |

Mix dry

Add water to field capacity
Pasteurize @ 140F for 12 hours (submerge in water with sous vide set to 142F and bags slightly open on top sticking out of the water so it can breathe)

After 12 hours let it slowly cool in the same water for another 12 hours. The substrate needs fresh air as it needs oxygen for the good bacteria that grow in symbiosis with the PanCyan - the so called thermophilic Actinobacillus.
After 24 hours Mix the grain with substrate in the monotub with the top air vents open (filtered off course) and make the mix 7cm thick.
Do not compress the substrate, make it as airy as possible because Panaeolus has a hard time getting through solid material. (Hence do not steralize the substrate)
This is also the reason why panaeolus normally prefers cow manure as it acts more like a liquid culture compared to horse manure. But the big problem with cow manure these days is that the cows are not eating grass anymore but corn and grain. This does not work as well. So you need cow manure from grass fed cows (the best).
But making horse manure more fluffy / airy with some vermiculite works just fine as well.
Colonization conditions:
Temperature: 26C
Humidity: 95%
So make the room 25C and the good bacteria in the substrate make it inside the monotub 26C

XXX XXX
A look inside a 120 liter monotub filled with Panaeolus Hawaii mycelium. Ready to be cased.
- After consolidation (when most of the soil is white) put a very thin casing layer on top at filed capacity.
Casing layer: 50% vermiculite @ PH 7.2 (use agricultural lime which is Calcium carbonate to lower the acidity to 7.2) |

Do not get the sphagum moss but make sure it is peat moss - cheap stuff but get rid of the wood chunks.. Sphagum peat moss is also ok. Basically you want the sand and not the moss.

Monotub cased
- Wait 12 hours after casing and then open the lower air holes and start the ultrasonic fogger and computer fan to start FC (fruiting condition)
FC:
Temperature: 26C
Humidity 90% (this is mostly achieved by the casing layer)
To help create pins inside a monotub, a computer fan with a fog generator really helps. Alsodaylight LED on a timer helps.
Fan 1 minute on, then Fan + Fogger 1min on, then Fogger 1 minute on, then Everything 15 minutes off. You need a "CMFR-66 time relay" - see below |
The idea is to evaporate the small water droplets on the surface first by using the fan for 1 minute. Evaporation helkps create premordia (pins)
Then remoisturise the monotub.
Best is to stop everything before the mushrooms start to release spores
, otherwise your filters will clog up with spores and the mushroom caps get too moist.
This is how to keep the power supply always on. Just use a paperclip. This way if you put the power supply on a timer it will work. |
CMFR-66 This is connected to the BN-LINK input and the output is connected to the fogger. It is set for a 1 minute delay to be turned on. So what happens is when the BN-LINK is turned on, the computer fan starts directly but the fogger has a 1 minute delay. |
BN-LINK Short Period Repeat Cycle Intermittent Timer The computer fan is on another BN-Link set for 2 minutes. The whole system is connected to a BN Link set for 3 minutes on and 15 minutes off. The LED lights are on a 24 hour timer, set for 14 hour on and 10 hours off cycle. |
Microppose filter on the inside of monotub with computer fan and mister outside What happens is when the first BN-LINK turns on for 3 minutes, it starts a second BN Link that is set for 2 minutes and turns on a computer fan. After 1 minute delay the CMFR-66 turns on the fogger. Because the first BN Link is set for 3 minutes, the fogger only works for 2 minutes. And because the second BN Link is set for 2 minutes, the fogger and fan run together for 1 minute and then only the fogger is on for the last minute. |

Panaeolus Bisporus with a bit of CO2 in the box

Also a bit too moist

Air breathing opening too high, causing the PanCyans to grow hairs on their feet :)
The most successful grower of PanCyans, Jakeoncid419 has made a great message board on shroomery: https://www.shroomery.org/forums/showflat.php/Number/25925194